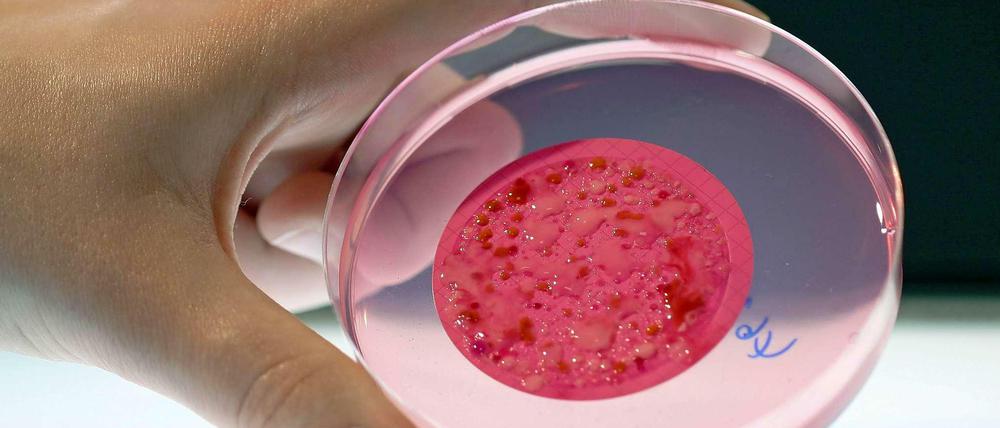

© Imago
Gesundheitsberufe: Petri Heil!
Biotechnologie, Medizintechnik, Pharma: Absolventen im Bereich Life Sciences haben in der Hauptstadtregion gute Aussichten.
Stand:
Über 220 Biotechnologiebetriebe, 280 Medizintechnik- und 30 Pharmaunternehmen, dazu rund 130 Kliniken und 24 große Forschungseinrichtungen und Universitäten mit dem Schwerpunkt Life Sciences: Die Region Berlin-Brandenburg ist einer der führenden europäischen Standorte für die „Lebenswissenschaften“ – gute Chancen für Fachkräfte mit passenden Qualifikationen.
„Im internationalen Biotech-Wettbewerb hat die Hauptstadtregion alle Trümpfe in der Hand“, sagt Kai Bindseil, Clustermanager Gesundheitswirtschaft Berlin-Brandenburg und seit 2001 Leiter des Aktionszentrums Biotop Berlin-Brandenburg, der zentralen Anlaufstelle für Fragen zur Biotechnologie in der Region. Die kurzen Wege zur Wissenschaft sind der Hauptgrund dafür, dass sich immer mehr nationale und internationale Firmen hier ansiedeln oder ihre Zentralen nach Berlin verlegen.
„Bei der Übertragung von Erkenntnissen aus der Forschung in die Anwendung geht es um weit mehr als die Entwicklung neuer Wirkstoffe oder die Gründung von Spin-offs“, sagt Clustersprecher Walter Rosenthal, Wissenschaftlicher Vorstand des Max- Delbrück-Centrums für Molekulare Medizin (MDC). Es gehe auch um neue Behandlungsstrategien und Diagnosewerkzeuge, angefangen bei der Prävention bis hin zur Rehabilitation.
Parallel zur Wirtschaft wächst das Ausbildungsangebot
Davon profitieren auch die Beschäftigten. Jeder achte Berliner ist in der Gesundheitswirtschaft tätig. Insgesamt zählt die Branche in Berlin-Brandenburg über 5700 Unternehmen. Die Industrie- und Handelskammer Berlin (IHK) bietet im Rahmen des Masterplans Gesundheitsregion Berlin-Brandenburg eine Reihe passender Aus- und Weiterbildungsmöglichkeiten an. So kann man sich zum Beispiel zum Biologie-, Chemie- und Physiklaboranten ausbilden lassen oder Pharmakant, Kaufmann im Gesundheitswesen oder Mikrotechnologin werden. Auch zu Sport- und Fitnesskaufleuten und Fachwirten im Sozial- und Gesundheitswesen können Interessierte sich qualifizieren. Zu einer Job-Recruitment-Initiative haben sich die Berliner Firmen aus der Medizintechnik zusammengefunden. Besonders gefragt sind Ingenieure, Vertriebsspezialisten mit naturwissenschaftlich-technischem Hintergrund, kaufmännisches Personal und Fachkräfte für Bürokommunikation.
Auch die Hochschulen in Berlin und Brandenburg haben auf die Bedürfnisse der Wirtschaft und die neuen technologischen Entwicklungen reagiert – mit inter- und transdisziplinären Life-Sciences-Studiengängen. So gibt es nicht nur medizinische, therapeutische und pflegebezogene Fächer, sondern auch Studiengänge wie Pharmazie, Biotechnologie, Public Health, Medizininformatik, Gerontologie und Ernährungswissenschaft.
Parallel zur Wirtschaft wächst damit auch das Angebot der akademischen Ausbildung: 170 Studiengänge mit engerem oder weiterem Gesundheitsbezug werden in Berlin und Brandenburg gezählt. Viele wurden erst in den vergangenen Jahren ins Leben gerufen.
Studiengänge für den Bereich Life Sciences kann man zum Beispiel unter www.atlas-studium.de oder www.studienfuehrer-bio.de finden.
Jacqueline Filla
- showPaywall:
- false
- isSubscriber:
- false
- isPaid: